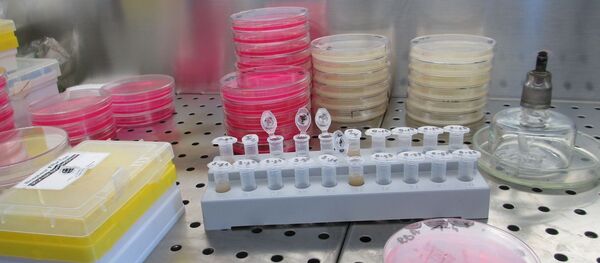
un laboratoire лаборатория - Sputnik Afrique

La première étape des essais cliniques d’un projet de vaccin contre le coronavirus, lancés aux États-Unis en avril, s’est terminée avec succès, a annoncé lundi 18 mai le laboratoire américain Moderna.
Summary of our SARS-CoV-2 #vaccine (mRNA-1273) interim Phase 1 data. Read more: https://t.co/aIq34ullAh #mRNA pic.twitter.com/BVbYuWTkOy
— Moderna (@moderna_tx) May 18, 2020
Selon ce dernier, le vaccin expérimental, baptisé mRNA-1273, a déclenché une réponse immunitaire chez les huit volontaires. Le nombre d’anticorps dans le sang des volontaires était supérieur ou égal à celui observé chez les personnes naturellement contaminées par le coronavirus SARS-CoV-2 qui provoque le Covid-19, d’après le communiqué.
Des essais à grandes échelle prévus en juillet
«Nous investissons pour augmenter la production afin de maximiser le nombre de doses que nous pouvons produire pour aider à protéger autant de personnes que possible contre le SARS-CoV-2», a indiqué Stéphane Bancel, PDG de Moderna.
Le prix des actions de l’entreprise a grimpé de 25% suite à ces annonces, a annoncé l’agence de presse Reuters.
Le laboratoire Moderna, dans lequel le gouvernement américain a investi 483 millions de dollars, a été l’un des premiers à se lancer dans la course mondiale au vaccin contre le nouveau coronavirus, rappelle l’agence France-Presse (AFP).